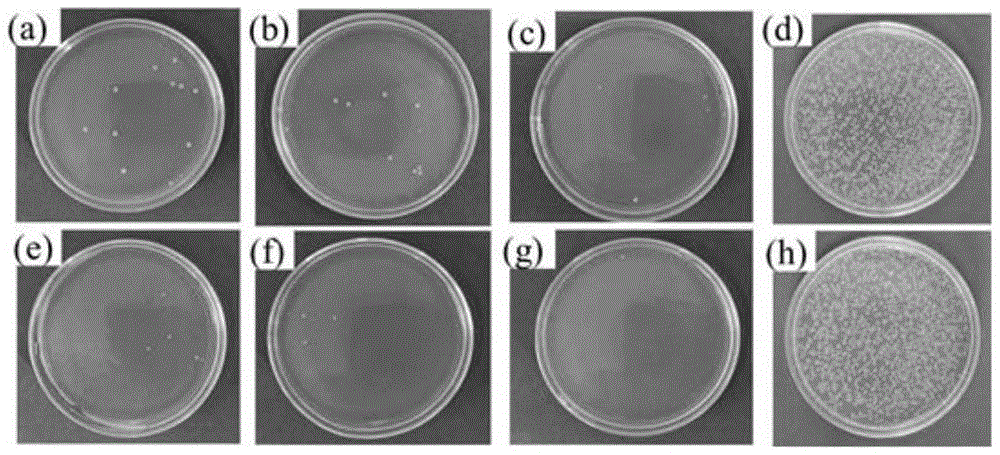

当前位置:首页 > 专利超市
专利类别:
专利类型:
行业分类:
- 不限
- A:人类生活需要
-
B:作业,运输
 全部 B01:一般的物理或化学的方法或装置 B02:破碎、磨粉或粉碎;谷物碾磨的预处理 B03:用液体或用风力摇床或风力跳汰机分离固体物料;从固体物料或流体中分离固体物料的磁或静电分离;高压电场分离 B04:用于实现物理或化学工艺过程的离心装置或离心机 B05:一般喷射或雾化;对表面涂覆液体或其他流体的一般方法 B06:一般机械振动的发生或传递 B07:将固体从固体中分离;分选 B08:清洁 B09:固体废物的处理;被污染土壤的再生 B21:基本上无切削的金属机械加工;金属冲压 B22:铸造;粉末冶金 B23:机床; 其他类目中不包括的金属加工 B24:磨削;抛光 B25:手工工具;轻便机动工具;手动器械的手柄;车间设备;机械手 B26:手工切割工具;切割;切断 B27:木材或类似材料的加工或保存;一般钉钉机或钉U形钉机 B28:加工水泥、粘土或石料 B29:塑料的加工;一般处于塑性状态物质的加工 B30:压力机 B31:纸品或纸板或类似纸的方式加工的材料制品制作;纸或纸板或类似纸的方式加工的材料的加工 B32:层状产品 B33:增材制造技术 B41:印刷;排版机;打字机;模印机 B42:装订;图册;文件夹;特种印刷品 B43:书写或绘图器具;办公用品 B44:装饰艺术 B60:一般车辆 B61:铁路 B62:无轨陆用车辆 B63:舰舶或其他水上船只;与船有关的设备 B64:飞行器;航空;宇宙航行 B65:输送;包装;贮存;搬运薄的或细丝状材料 B66:卷扬;提升;牵引 B67:开启或封闭瓶子、罐或类似的容器;液体的贮运 B68:鞍具;家具罩面 B81:微观结构技术 B82:超微技术 B99:本部其他类目中不包括的技术主题
全部 B01:一般的物理或化学的方法或装置 B02:破碎、磨粉或粉碎;谷物碾磨的预处理 B03:用液体或用风力摇床或风力跳汰机分离固体物料;从固体物料或流体中分离固体物料的磁或静电分离;高压电场分离 B04:用于实现物理或化学工艺过程的离心装置或离心机 B05:一般喷射或雾化;对表面涂覆液体或其他流体的一般方法 B06:一般机械振动的发生或传递 B07:将固体从固体中分离;分选 B08:清洁 B09:固体废物的处理;被污染土壤的再生 B21:基本上无切削的金属机械加工;金属冲压 B22:铸造;粉末冶金 B23:机床; 其他类目中不包括的金属加工 B24:磨削;抛光 B25:手工工具;轻便机动工具;手动器械的手柄;车间设备;机械手 B26:手工切割工具;切割;切断 B27:木材或类似材料的加工或保存;一般钉钉机或钉U形钉机 B28:加工水泥、粘土或石料 B29:塑料的加工;一般处于塑性状态物质的加工 B30:压力机 B31:纸品或纸板或类似纸的方式加工的材料制品制作;纸或纸板或类似纸的方式加工的材料的加工 B32:层状产品 B33:增材制造技术 B41:印刷;排版机;打字机;模印机 B42:装订;图册;文件夹;特种印刷品 B43:书写或绘图器具;办公用品 B44:装饰艺术 B60:一般车辆 B61:铁路 B62:无轨陆用车辆 B63:舰舶或其他水上船只;与船有关的设备 B64:飞行器;航空;宇宙航行 B65:输送;包装;贮存;搬运薄的或细丝状材料 B66:卷扬;提升;牵引 B67:开启或封闭瓶子、罐或类似的容器;液体的贮运 B68:鞍具;家具罩面 B81:微观结构技术 B82:超微技术 B99:本部其他类目中不包括的技术主题 -
C:化学,冶金
 全部 C01:无机化学 C02:水、废水、污水或污泥的处理 C03:玻璃;矿棉或渣棉 C04:水泥;混凝土;人造石;陶瓷;耐火材料 C05:肥料;肥料制造 C06:炸药;火柴 C07:有机化学 C08:有机高分子化合物;其制备或化学加工;以其为基料的组合物 C09:染料;涂料;抛光剂;天然树脂;粘合剂; 其他类目不包含的组合物;其他类目不包含的材料的应用 C10:石油、煤气及炼焦工业;含一氧化碳的工业气体;燃料;润滑剂;泥煤 C11:动物或植物油、脂、脂肪物质或蜡;由此制取的脂肪酸;洗涤剂;蜡烛 C12:生物化学;啤酒;烈性酒;果汁酒;醋;微生物学;酶学;突变或遗传工程 C13:糖工业 C14:小原皮;大原皮;毛皮;皮革 C21:铁的冶金 C22:冶金;黑色或有色金属合金;合金或有色金属的处理 C23:对金属材料的镀覆;用金属材料对材料的镀覆;表面化学处理;金属材料的扩散处理;真空蒸发法、溅射法、离子注入法或化学气相沉积法的一般镀覆;金属材料腐蚀或积垢的一般抑制 C25:电解或电泳工艺;其所用设备 C30:晶体生长 C40:组合技术 C99:本部其他类目中不包括的技术主题
全部 C01:无机化学 C02:水、废水、污水或污泥的处理 C03:玻璃;矿棉或渣棉 C04:水泥;混凝土;人造石;陶瓷;耐火材料 C05:肥料;肥料制造 C06:炸药;火柴 C07:有机化学 C08:有机高分子化合物;其制备或化学加工;以其为基料的组合物 C09:染料;涂料;抛光剂;天然树脂;粘合剂; 其他类目不包含的组合物;其他类目不包含的材料的应用 C10:石油、煤气及炼焦工业;含一氧化碳的工业气体;燃料;润滑剂;泥煤 C11:动物或植物油、脂、脂肪物质或蜡;由此制取的脂肪酸;洗涤剂;蜡烛 C12:生物化学;啤酒;烈性酒;果汁酒;醋;微生物学;酶学;突变或遗传工程 C13:糖工业 C14:小原皮;大原皮;毛皮;皮革 C21:铁的冶金 C22:冶金;黑色或有色金属合金;合金或有色金属的处理 C23:对金属材料的镀覆;用金属材料对材料的镀覆;表面化学处理;金属材料的扩散处理;真空蒸发法、溅射法、离子注入法或化学气相沉积法的一般镀覆;金属材料腐蚀或积垢的一般抑制 C25:电解或电泳工艺;其所用设备 C30:晶体生长 C40:组合技术 C99:本部其他类目中不包括的技术主题 - D:纺织;造纸
- E:固定建筑物
-
F: 机械工程;照明;加热;武器;爆破
 全部 F01:一般机器或发动机;一般的发动机装置;蒸汽机 F02:燃烧发动机;热气或燃烧生成物的发动机装置 F03: 液力机械或液力发动机;风力、弹力或重力发动机;其他类目中不包括的产生机械动力或反推力的发动机 F04:液体变容式机械;液体泵或弹性液体泵 F15:流体压力执行机械;一般液压技术和气动技术 F16:工程元件或部件;为产生和保持机器或设备的有效运行的一般措施;一般绝热 F17:气体或液体的贮存或分配 F21:照明 F22:蒸汽的发生 F23:燃烧设备:燃烧方法 F24:供热;炉灶;通风 F25:制冷或冷却;加热和制冷的联合系统;热泵系统;冰的制造或储存;气体的液化或固化 F26:干燥 F27:炉;窑;烘烤炉;蒸馏炉 F28:一般热交换 F41:武器 F42:弹药;爆破 F99:本部其他类目中不包括的技术主题
全部 F01:一般机器或发动机;一般的发动机装置;蒸汽机 F02:燃烧发动机;热气或燃烧生成物的发动机装置 F03: 液力机械或液力发动机;风力、弹力或重力发动机;其他类目中不包括的产生机械动力或反推力的发动机 F04:液体变容式机械;液体泵或弹性液体泵 F15:流体压力执行机械;一般液压技术和气动技术 F16:工程元件或部件;为产生和保持机器或设备的有效运行的一般措施;一般绝热 F17:气体或液体的贮存或分配 F21:照明 F22:蒸汽的发生 F23:燃烧设备:燃烧方法 F24:供热;炉灶;通风 F25:制冷或冷却;加热和制冷的联合系统;热泵系统;冰的制造或储存;气体的液化或固化 F26:干燥 F27:炉;窑;烘烤炉;蒸馏炉 F28:一般热交换 F41:武器 F42:弹药;爆破 F99:本部其他类目中不包括的技术主题 - G:物理
- H:电学
- 其他
专利状态:
合作方式:
已选条件: